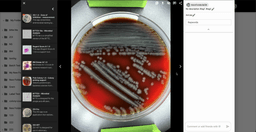
Screenshot of a ListPage in Saas UI Pro

Accelerating Insights
in Life Sciences
with AI and Collaboration
in Life Sciences
with AI and Collaboration
that facilitates image analysis and real-time communication in the medical, healthcare, and research fields.

Easy to use
Designed for ease of use and productivity in mind.
Collaborative
Work together with your team in real-time.
Productive
Be productive and focus on your work without wasting time on manual measurement and calculations.
Connections
Connect with other professionals and get help in real-time for better diagnosis.
Masakazu Nakajima
Co-founder & CEO
Revolutionize Healthcare Collaboration with CarbConnect
CarbConnect is a cloud-based platform that leverages advanced AI-driven image analysis and real-time collaboration to transform healthcare and research, enabling more efficient diagnosis and faster scientific breakthroughs.
- AI image analysiscloud-based platformhealthcare collaborationresearch image interpretationreal-time communicationzone of inhibitionNugent scoreblood classificationgram stainbacteria identification
Powerful Features
for Advanced Image Analysis
Discover how our platform can transform your workflow and drive innovation in healthcare and research.
AI Image Analysis
Utilize cutting-edge AI algorithms for precise and efficient image analysis.
Cloud-Based Platform
Securely access and manage your data from anywhere with our cloud-based infrastructure.
Healthcare Collaboration
Collaborate seamlessly with healthcare professionals to enhance patient care and outcomes.
Research Image Interpretation
Enhance your research with advanced image interpretation tools tailored for scientific discovery.
Real-Time Communication
Engage in instant communication with your team for quicker decision-making and coordination.
Zone of Inhibition Analysis
Accurately measure and analyze zones of inhibition in microbiological assays with ease.
Nugent Score Calculation
Quickly calculate Nugent scores for bacterial vaginosis diagnosis using automated tools.
Blood Cell Classification
Classify and differentiate blood cells accurately with sophisticated algorithms.
Gram Stain Interpretation
Perform and interpret Gram stain results efficiently for bacterial identification.
Bacteria Identification
Identify bacterial species swiftly to support effective treatment plans.
Pricing for every stage
Subscribe to a plan that fits your needs.
or
Start Free Today
Entry
JPY 1500 / monthly
Standard
JPY 3500 / monthly
Payment Methods
Bank Transfer
Powered by
Our plans offer different levels of access and benefits to suit your needs at every stage of your project.
Pricing for Applications
ZOI 1.0 - Zone of Inhibition measurement
BiTTE® lite
Nugent Score AI 1.0
BM Smear AI 1.0
ZOI Pro - Zone of Inhibition measurement
Colony Counter
Pick Colony 1.0 - Colony picking support
ZOI VET
BiTTE® - Microbial Analysis
Payment Methods
Bank Transfer
Powered by
Our applications provide AI-driven image analysis and enable real-time collaboration to boost efficiency and accuracy in your diagnostic workflows.
Frequently asked questions
- Can CarbConnect be used for cloud-based storage of image files?
- Yes, CarbConnect provides secure, cloud-based storage for image files, ensuring accessibility from anywhere. Its platform safeguards data integrity and supports real-time collaboration among users.
- What are the benefits of using CarbConnect for real-time image sharing?
- CarbConnect allows users to share image data instantly, facilitating quick feedback and expert collaboration. Real-time sharing accelerates decision-making and enhances coordination among professionals.
- What are the key features of the CarbConnect platform?
- CarbConnect features include AI-powered image analysis, secure cloud-based storage, real-time sharing, and integrated communication tools. It supports automation, standardization, and seamless collaboration for researchers and medical professionals.
- How can AI assist in Zone of Inhibition analysis?
- AI assists by analyzing images of bacterial growth and the inhibition zone, providing accurate and consistent measurements. It can also classify bacterial responses and generate detailed reports, streamlining the analysis process.
White Papers
- Generative AI & LLMs: Transforming Microbial Image Analysis
- Discover how generative AI and large language models are reshaping microbial image analysis. By leveraging deep learning, cloud-based automation, and data-driven insights, CarbConnect tackles scalability and accuracy gaps in conventional diagnostic workflows. This paper shows how AI unites manual observation with automated analysis, offering practical guidance and a glimpse into future directions. Learn more about Generative AI & LLMs: Transforming Microbial Image Analysis
- AI-Powered Gram Stain Image Analysis for Microbial Classification and Diagnostics
- Introduced by Hans Christian Gram in 1884, Gram staining remains pivotal for distinguishing Gram-positive from Gram-negative bacteria. This paper examines an AI-supported approach to Gram stain image analysis, detailing how early detection of bacterial forms and classification can steer precise treatment choices in clinical settings. Learn more about AI-Powered Gram Stain Image Analysis for Microbial Classification and Diagnostics
- Revolutionizing Vaginal Health Diagnostics: AI-Powered Nugent Scoring and the Future of Microbiome Assessment
- Automated Nugent scoring systems are emerging as a promising approach to standardize and accelerate the diagnosis of bacterial vaginosis through Gram-stain image interpretation. As personalized and microbiome-aware medicine gains prominence in women’s health, AI-driven tools are offering new pathways for consistent, rapid, and objective assessment of vaginal flora. This white paper examines recent innovations in vaginal health diagnostics and highlights Nugent Score AI as one example of such developments within this evolving field. One example of such a system is Nugent Score AI by CarbGeM, which uses AI to interpret Gram-stained slides and provide standardized Nugent score classifications. Learn more about Revolutionizing Vaginal Health Diagnostics: AI-Powered Nugent Scoring and the Future of Microbiome Assessment
- Revolutionizing Antimicrobial Susceptibility Testing: How AI and Automation Improve Zone of Inhibition Analysis
- Antimicrobial susceptibility testing (AST) plays a central role in modern infectious disease management. It allows clinicians to determine whether a specific pathogen is susceptible, intermediate, or resistant to a given antimicrobial agent, ensuring that patients receive the most appropriate therapy. In the face of growing antimicrobial resistance (AMR), AST is not only essential for individual patient outcomes but also critical for public health, antimicrobial stewardship, and surveillance. Learn more about Revolutionizing Antimicrobial Susceptibility Testing: How AI and Automation Improve Zone of Inhibition Analysis
- Leveraging AI for Microbial Diagnostics and Research in Resource-Limited Settings
- In an increasingly interconnected world, healthcare disparities continue to pose significant challenges, especially in resource-limited areas. These challenges are not confined to low- and middle-income countries (LMICs) but extend to suburban regions of developed nations, remote communities, and even healthcare settings operating during off-hours, such as night shifts. Additionally, the aging populations of many developed countries and the ongoing global healthcare labor shortage further exacerbate these issues. Learn more about Leveraging AI for Microbial Diagnostics and Research in Resource-Limited Settings
- Revolutionizing Antimicrobial Susceptibility Testing: How AI and Automation Improve Zone of Inhibition AnalysisEmpowering Veterinary Diagnostics with Disk Diffusion AST: Global Trends and the Future with AI
- Antimicrobial susceptibility testing (AST) via disk diffusion remains a globally adopted, cost-effective method in veterinary diagnostics, particularly in livestock health. This white paper explores current global and domestic trends, challenges, and innovations in the field, emphasizing the ongoing relevance of disk diffusion and the transformative potential of AI-powered tools. It highlights the emergence of AI-powered tools aimed at standardizing and enhancing AST practices in veterinary settings, including innovations designed specifically for livestock applications. Learn more about Revolutionizing Antimicrobial Susceptibility Testing: How AI and Automation Improve Zone of Inhibition AnalysisEmpowering Veterinary Diagnostics with Disk Diffusion AST: Global Trends and the Future with AI